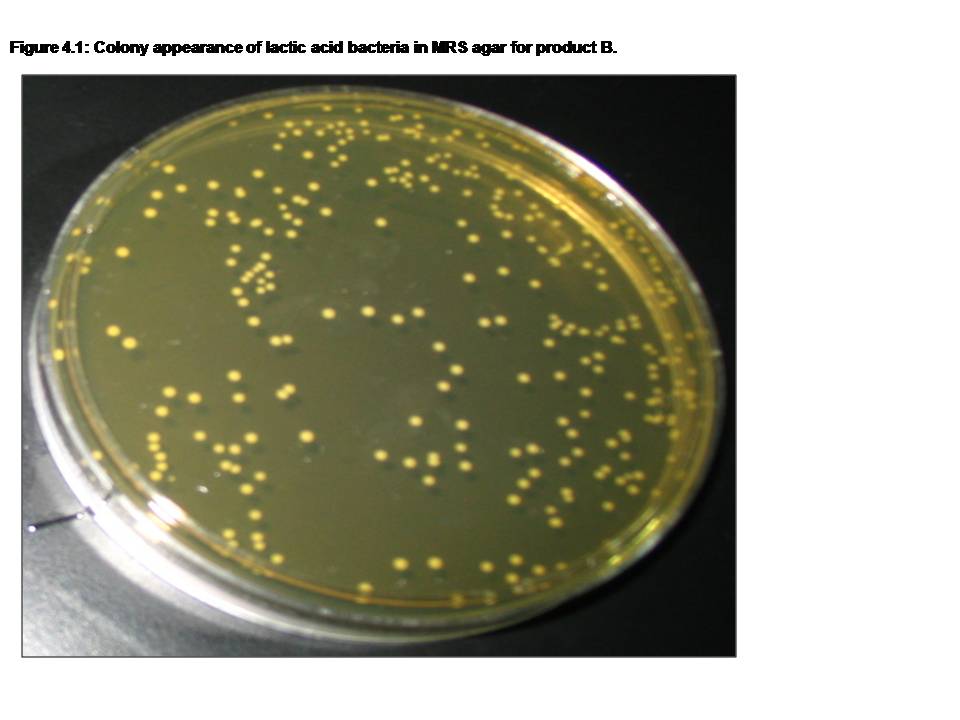

Рост на мпа
Создание таблицы макросом
Модная женская одежда это
54 в 10 системе счисления в 5
12 аренда это
Агту заочное
Бит стрит рязань
Истории кота бегемота аудио
Мясорубка производства белоруссии
Аналоги метопролол 50 органика
Сварка трубы 426
Квартиры на стальского омск
Где находится это место которое было
Flying rope
Рост на мпа 111 фотографий